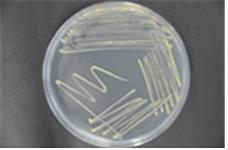
그림3-해당화 내생균류 배양체.jpg

극한 환경 생물의 성장과 치유를 돕는 미생물
질주하던 더위가 오버랩(Overlap)도 없이 꺾였다. 무더위로 인한 전력소비가 사상 최고로 치솟을 만큼 극한(極限) 여름이었다는 이야기를 한다. 독일의 실존주의 철학자 카를 야스퍼스(Karl Jaspers, 1883~1969)는 ‘극한 상황(極限狀況)’이란 일반적이지 않고 어려운 형편으로 현재의 존재를 한계 짓는 궁극적인 상황이라고 정의한다. 그에 의하면, 극한 상황의 경험은 인간을 고독과 절망 속으로 몰아넣지만 이를 회피하지 않고 존재 자체에 대한 각성과 신앙을 갖게 될 때 참다운 자신을 발견한다고 설명한다. 여기서 신앙은 종교적 관점에서의 해석도 가능하나 ‘강한 의지’와 ‘운’으로 대신할 수도 있겠다.
# 천리포 수목원의 특별함
1945년 한국과 첫 인연을 맺게 된 칼 페리 밀러(Carl Ferris Miller, 1921~2002)는 한국 이름이 민병갈이다. 화학과 일본어를 전공하고 한국의 금융업계에 종사했다. 식물에 깊은 관심이 있어 1962년 바닷가의 모래언덕 1ha(3,000평)를 시작으로 현재의 ‘천리포 수목원’을 조성하게 된다. 천리포 수목원은 태안반도 천리포 해변에 자리 잡은 우리나라 최초의 사립수목원이다.
 천리포 수목원
천리포 수목원수목원이 설립되기 이전 모래언덕은 몇 그루의 해송과 사구식물들이 듬성듬성 자라던 황무지였다. 그는 가장 먼저, 식물이 자랄 수 있는 환경을 만들기 위해 방풍림을 심고 모래땅에 물을 공급하기 위한 연못을 팠다. 척박한 환경에 적합한 식물로 목력속, 감탕나무속, 동백나무속, 단풍나무속, 무궁화속을 식재하여 현재 국내 최다인 15,600종의 식물을 보유하고 있다. 아시아 최초로 국제 수목 학회로부터 ‘세계의 아름다운 수목원(2000년)’으로 인정받았고 설립자의 뜻을 이어 지금도 수목원의 관리와 보전, 연구에 정성을 다하고 있다.
“천리포 수목원이 식물들의 피난처로, 식물 전공자를 위한 연구공간으로, 나무사랑 정신을 일깨우는 교육공간으로 남기를 바란다.”는 그는 나무가 주인이며 나무가 행복한 공간의 특별한 인연이 되었다. 1970년대 도시계획으로 사라질 위기에 처한 한옥과 초가집을 보존하고 있다는 점도 수목원의 특징이다. 개인 수목원답게 수목원의 출구에는 그에 어울리는 아기자기한 기념품 숍이 있다. 수목원을 알리는 예쁜 책들과 작은 꽃, 화분, 식물 뿌리 그리고 허브향이 나는 차와 스트레스 해소에 좋다는 액체 스프레이, 오염된 균을 제거하는 세제 등을 판매한다. 판매 담당자는 모두 천연 식물재료로 만들었다고 친절하게 설명한다.
문득 해안가에서 자라는 식물과 주변 환경의 관계에 대한 의문이 생긴다. 과학적으로 증명될 수 있는 무언가가 있다는 생각에 척박한 모래밭 식물들의 생육 비밀을 밝히기 위해 수목원 근처의 바닷가로 향했다.
# 신두리 해안사구를 지키는 그들만의 방법
뜨거운 여름을 보낸 바닷가는 휴가철이 마무리된 지금, 조용하다. 아니다. 소란하지 않을 뿐 분주하고 바쁘다. 해수면이 밀려간 썰물의 모래밭은 독특한 생태계를 형성한다. 넓은 모래밭은 염낭게류와 콩게류가 집을 지을 수 있는 공간이며 거대한 음식 창고이다. 이들은 모래 위의 자기 영역을 지키고 더 큰 집을 차지하기 위해 서로 싸운다. 동시에 밀물이 되기 전에 모래 속의 부유물들을 열심히 걸러먹고 걸러진 모래들을 집 밖으로 실어 날라야 한다. 크고 작은 모래 덩어리는 순식간에 모래 위의 예술이 된다. 그 규모가 거대하고 촘촘하여 발을 디딜 틈도 없다. 무심한 발놀림에 놀란 도약옆새우류들이 화들짝 튀어 오른다.
 신두리 해안사구
신두리 해안사구해변을 둘러싼 신두리 해안사구의 모습은 아름답다. 바다가 낳은 아들이라고 하든가, 자연이 무엇을 만들고 남길 때는 의미가 있다. 언뜻 보기에는 척박한 모래밭이라고 생각할 수 있고 뜨거운 햇빛과 바닷바람, 농도 높은 염분, 그저 그런 메마른 토양이라고 여길 수 있다. 그러나 신두리 해안사구는 천연기념물 제431호로 그 환경에 맞는 생물이 다양하게 존재하고 있는 생태계 보전지역이다.
태안반도의 서쪽과 북쪽을 가로지르며 형성된 약 3.4km의 모래언덕은 해안과 내륙 사이에서 완충 공간의 역할을 한다. 태풍이나 해일로 인한 해안선의 침식을 막고 담수를 지하에 저장하여 습지를 제공한다. 그래서 척박한 모래언덕 주변을 비옥하게 만들어 준다. 해안사구는 바람에 의해 이동이 잦다. 이러한 모래의 움직임을 견디고 건조한 토양에서 생육하는 식물들에게는 강한 저항력이 있다. 우리가 흔히 알고 있는 강아지풀과 갯방풍, 좀보리사초 등이 선구식물(先驅植物)에 속하며 해안의 모래에 최초로 정착하는 식물들이다. 선구식물들의 성장은 모래의 이동을 줄이고 해변 생물들이 함께 서식할 수 있는 안정된 생육환경을 만든다.
사구를 따라 걷다 보면 모래 깊이 뿌리내린 순비기나무와 꽃이 진 해당화 나무가 눈에 들어온다. 흥미로운 것은 극한 환경에 노출되어 강한 저항력을 키운 해당화 나무의 뿌리와 주변 흙에서 미생물이 발견되었다는 점이다(2013년, 국립생물자원관). 발견된 내생균류와 근권 세균은 식물의 성장과 저항력 증진으로 식물을 보호해 준다는 연구결과가 나왔다.
# 미생물, 이롭고 해롭고 다시 이롭고
최근 극한환경(極限環境, Extreme environment)이나 특수 환경(特殊環境)의 미생물(효소산업 및 생물전환 공정 산업의 주요 소재로 주목받고 있음)을 체계적으로 확보하여 이용가치를 연구하고 미생물의 잠재된 자원력을 활용할 수 있는 생명공학 산업이 화두가 되고 있다.
우리는 미세먼지와 오염으로부터 몸을 보호하기 위해 멸균이나 항균제품을 판단 없이 사용하고 있다. 미생물로부터 저항하기 위해 사용하는 제품들은 미생물들의 저항력을 증진시키고 오히려 내성을 키워준다. 즉 열악한 환경에서도 살아남을 수 있는 미생물들이 별도로 존재하게 되었으며 이들을 극한 미생물(極限 微生物)이라고 한다. 극한 미생물이란 뜨거운 온도(thermophilic, 好熱性), 높거나 낮은 pH(acidophil, 好酸性), 높은 염도(halophilic, 好塩性), 산소가 없는 환경(anaerobic, 嫌氣性), 방사선에 노출된 환경 등에서 살아남은 미생물을 지칭한다.
 해당화 나무 근권 세균 배양체
해당화 나무 근권 세균 배양체극한 미생물 중에는 방사능 오염지역 정화와 방사능에 노출된 환자의 치료 등이 가능한 것들도 있다. 다이노코쿠스 라디오듀런스(Deinococcus radiodurans)를 연구하는 해외 연구자들은 이 극한 미생물에 들어있는 고농도 망간화합물이 특정 단백질의 DNA 복구능력을 향상시킨다고 예측한다. 마치 마블영화의 ‘울버린’이 깊은 상처를 스스로 치유하는 것처럼 말이다.
Methanomethylovorans upoensis (경상남도 창녕군 우포늪: 람사르 습지 2013년, 강명석 제공)
Methanomethylovorans upoensis (경상남도 창녕군 우포늪: 람사르 습지 2013년, 강명석 제공)ICT(Information and Communications Technologies)가 경제산업의 기반이 되고 있으며 4차 산업혁명을 맞이하고 있는 현재, 우리는 과학과 의학기술의 핵심이 될 수 있는 미생물에 대해 어디까지 알고 있는가? 안타깝지만 빙산의 일각도 연구하지 못했다는 전문가들의 이야기가 있다. 자연계에는 우리가 모르는 미생물 자원이 상당수 존재하며 이러한 미생물의 확보와 연구는 국가적 차원에서 매우 중대한 일이다. 또한 우리의 삶에 안전하고 건강하게 공유, 응용될 수 있도록 다각도의 노력이 필요하다. 그렇다면 인간에게 이로운 미생물은 무엇이고 해로운 미생물은 무엇인가? 이에 대해 미국 캘리포니아 대학의 미생물학자인 조나단 아이젠(Jonathan Eisen) 박사는 다음과 같이 이야기한다.
“미생물은 어떤 때는 유익하고 어떤 때는 해로운 것이지 항상 유익하거나 항상 해로운 미생물은 없다.”
위 글은 2016년 넥스트 데일리에 게재된 칼럼입니다.
* 자료 도움 : 천리포 수목원, 국립생물자원관 미생물자원과 연구사 이학박사 강명석
